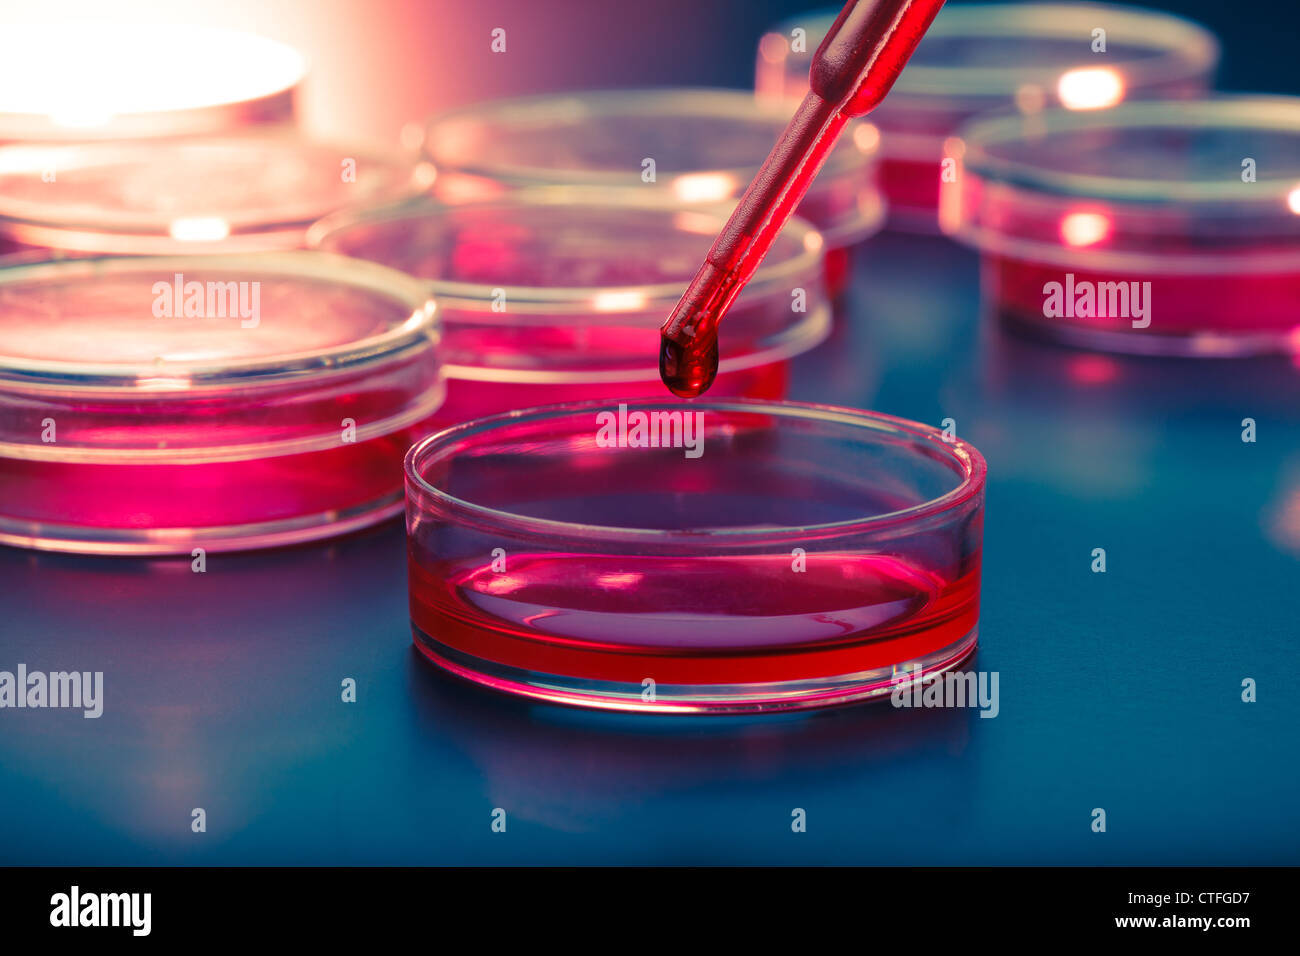
Pipette mit Tropfen Flüssigkeit und Petrischalen Stockfoto

Chemische pipette Stockfotos & Bilder

RFHNY5KP–Ein junger Chemiker Reagenzglas mit Flüssigkeit während chemisches Experiment zu halten. Assistent im Labor mit der Pipette Forschung von Krebsstammzellen. Weiblich

RFHNY5KE–Ein junger Chemiker Reagenzglas mit Flüssigkeit während chemisches Experiment zu halten. Assistent im Labor mit der Pipette Forschung von Krebsstammzellen. Weiblich

RFHNY5K9–Ein junger Chemiker Reagenzglas mit Flüssigkeit während chemisches Experiment zu halten. Assistent im Labor mit der Pipette Forschung von Krebsstammzellen. Weiblich

RFHNY5KH–Ein junger Chemiker Reagenzglas mit Flüssigkeit während chemisches Experiment zu halten. Assistent im Labor mit der Pipette Forschung von Krebsstammzellen. Weiblich

RFHNY5JM–Ein junger Chemiker Reagenzglas mit Flüssigkeit während chemisches Experiment zu halten. Assistent im Labor mit der Pipette Forschung von Krebsstammzellen. Weiblich

RFMHMGAY–Student Frau mit multi Pipette und andere PCR-Produkte in der mikrobiologischen/genetischen Labor

RFMHR7P9–Student Frau mit multi Pipette und andere PCR-Produkte in der mikrobiologischen/genetischen Labor

RFMHR7PF–Student Frau mit multi Pipette und andere PCR-Produkte in der mikrobiologischen/genetischen Labor

RFMHMG9X–Student Frau mit multi Pipette und andere PCR-Produkte in der mikrobiologischen/genetischen Labor

RFGFPNXG–Chemisches Laboratorium Szene: attraktive junge Studentin Wissenschaftler beobachten die blaue Anzeige Farbverschiebung nach der Lösung

RFGFPNXN–Chemisches Laboratorium Szene: attraktive junge Studentin Wissenschaftler beobachten die blaue Anzeige Farbverschiebung nach der Lösung